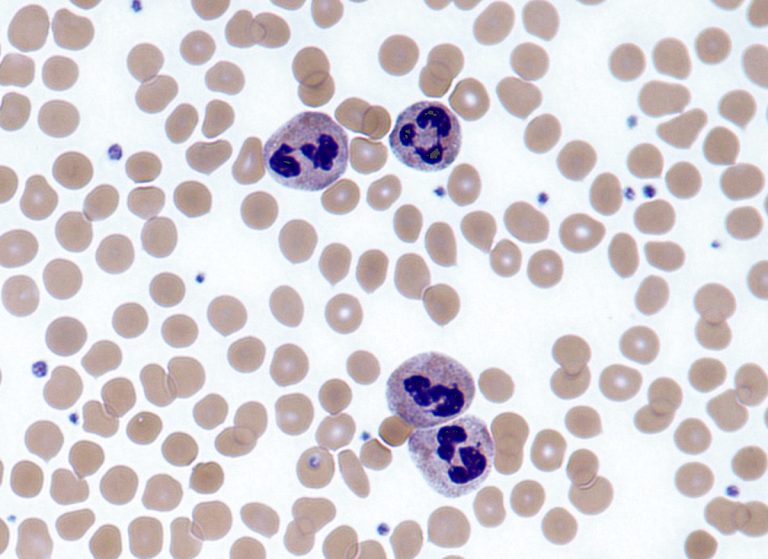

Profesionales de la Universidad de Virginia (Estados Unidos) identificaron como los antibióticos hacen que los neutrófilos, un...
Día: 24 de agosto de 2017
Congresistas demócratas han pedido a una psiquiatra de la Facultad de Medicina de Yale que se sume...
Tras la patente concedida, Pfizer podrá seguir controlando el mercado de PCV (vacuna neumocócica conjugada) en India...
El grupo de espionaje cibernético Fancy Bears volvió a asomar sus narices y esta vez, para lanzar...
Selección Argentina 2010 / Foto AFP El coordinador médico de la selección argentina, Donato Villani, aseguro...